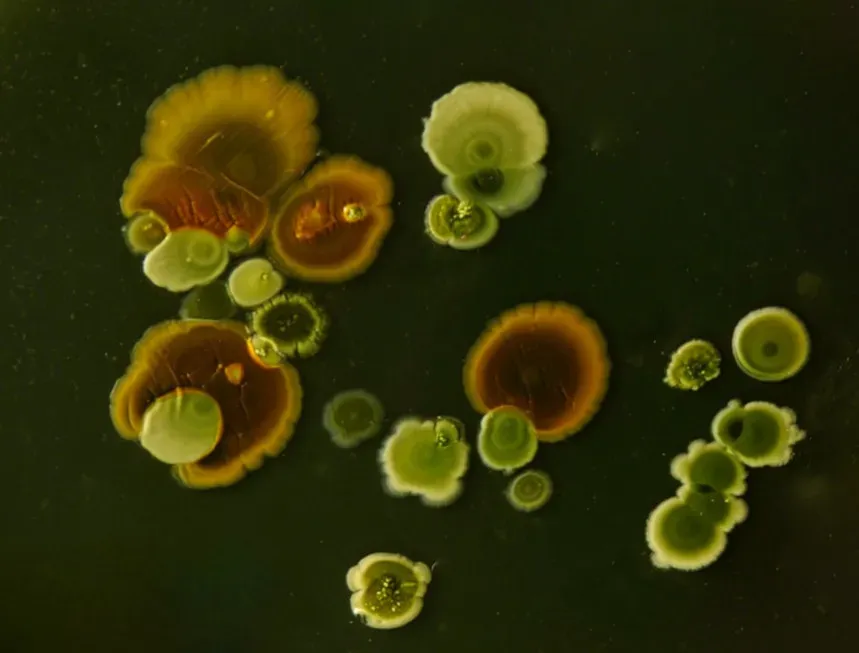
Microbial weather makers and climate shapers (Image Credits: Unsplash)

If you could suddenly see every microbe around you, it would probably feel overwhelming, maybe even a little terrifying. They are on your skin, in your lungs, covering your phone, floating in the air you just breathed in. Yet, without this invisible universe of tiny life forms, the world you know would simply fall apart.
Microbes built the atmosphere we breathe, help grow the food we eat, and even train our immune systems. They quietly run most of Earth’s major life-support systems while we barely notice they exist. Once you step into their world, it’s hard not to see everything around you a little differently.
The invisible majority: more microbes than stars

It sounds like science fiction, but the number of microbes on Earth is mind-bendingly large, estimated at around a nonillion individual cells, a one followed by thirty zeros. That’s more microbial cells than there are stars in the observable universe, and they live in places we once thought were completely lifeless. Microbes thrive miles beneath the ocean floor, in boiling hot springs, in acidic mine runoff, and inside Antarctic ice, quietly persisting where almost nothing else can survive.
What’s even wilder is how much of life’s diversity they represent. By some estimates, the vast majority of the planet’s genetic diversity is microbial, meaning most of life’s “creative experiments” are happening at that scale we can’t see. When scientists sequence DNA from soil, seawater, or even a spoonful of compost, they often find thousands of microbial species, many of which have never been named or grown in a lab. It’s like reading the first few pages of a book and realizing the rest of the chapters haven’t even been translated yet.
Microbes that breathe rock and eat pollution

One of the most surprising things about microbes is how flexible their “diet” can be. While we rely mostly on organic food and oxygen, many microbes use things we’d never call food at all: iron, sulfur, methane, even tiny amounts of hydrogen gas leaking from rocks. In deep mines and under the seafloor, some microbial communities survive almost entirely on energy coming from the chemistry of rocks and fluids, not from sunlight. In a way, they live in a world powered by geology instead of daylight.
This strange metabolism turns out to be incredibly useful for us. Certain bacteria can break down oil, pesticides, and industrial toxins, transforming them into less harmful substances. Engineers and environmental scientists use these microbes in bioremediation projects to clean up oil spills, contaminated groundwater, and even heavy metals. Watching microbes slowly detoxify an area is a bit like watching moss reclaim a ruined building: patient, silent, but surprisingly powerful.
The architects of the air we breathe

If you could travel back in time more than two billion years, you’d land on a planet where you couldn’t breathe the air. Early Earth’s atmosphere had almost no oxygen, and the sky might have looked very different. The shift from that alien world to the oxygen-rich planet we know today happened largely because of tiny photosynthetic microbes in the oceans. These ancient microbes, similar to today’s cyanobacteria, used sunlight to split water and release oxygen as a byproduct.
Over hundreds of millions of years, that microbial oxygen built up in the atmosphere and oceans, utterly transforming the planet. This event, often called the Great Oxygenation, made complex life possible but also wiped out many organisms that couldn’t handle oxygen. It’s ironic: something we think of as life-giving was once a deadly waste product. Even now, ocean microbes produce a huge share of the oxygen we rely on, turning vast stretches of ocean into invisible oxygen factories.
Soil microbes: the quiet farmers under our feet

Healthy soil isn’t just dirt; it’s a bustling city of microbes working nonstop. Bacteria, fungi, and other microscopic organisms break down dead leaves, roots, and organic matter, turning them into nutrients plants can actually use. Without this slow, steady recycling, nutrients would get locked away, and fields, forests, and gardens would gradually starve. When you smell that “earthy” scent after rain, you’re literally smelling chemicals made by soil microbes going about their daily business.
Some soil microbes form partnerships with plant roots, trading nutrients for sugars like a long-term business deal. Certain bacteria living on the roots of legumes such as beans and peas pull nitrogen from the air and convert it into forms plants need, helping fertilize the soil naturally. Others form vast underground networks of fungal threads, connecting trees and plants in what some researchers call a kind of “wood-wide web.” These microbe-root alliances can make plants more resilient to drought, disease, and poor soils, quietly boosting entire ecosystems and harvests.
Our inner ecosystem: the human microbiome

Every one of us carries a rich world of microbes inside and on our bodies, with the largest community living in our gut. There are roughly as many microbial cells in and on you as there are human cells, and together they help digest food, make vitamins, train your immune system, and even influence inflammation. I still remember the first time I saw a graphic comparing the diversity of microbes in a healthy gut to a tropical rainforest; that image completely changed how I thought about “me.”
Research over the past couple of decades has linked differences in the microbiome to conditions like obesity, inflammatory bowel disease, allergies, and even mood disorders. While it’s easy to get carried away and blame microbes for everything, it’s becoming clear that what we eat, where we live, and how often we take antibiotics all shape this inner ecosystem. In a way, every meal you eat is casting a vote for which microbial communities you want to support. Thinking of your body as a shared space rather than a solo act can feel strange, but it’s surprisingly freeing too.
Microbial weather makers and climate shapers
Microbes don’t just affect our bodies and soils; they also help shape weather and climate. Some bacteria floating in the atmosphere can act as tiny seeds for ice crystals, helping clouds form snow or rain. When they rise from oceans, forests, or fields, they can nudge local weather patterns in subtle ways, like invisible puppeteers tugging on strings we can’t see. It feels almost eerie to realize that the start of a snowfall might depend on a microscopic cell drifting through a cloud.
On a larger scale, microbes are deeply involved in Earth’s carbon cycle. Ocean microbes absorb carbon dioxide through photosynthesis, locking some of it away in deep waters when they die and sink. Others produce or consume powerful greenhouse gases like methane and nitrous oxide. This means that shifts in microbial communities, whether from warming oceans, pollution, or changing land use, can feed back into climate change. Understanding these microbial players is becoming one of the key challenges in predicting our climate future.
Microbes, pandemics, and prevention

Of course, when most people hear the word “microbe,” they think of disease: flu viruses, food poisoning bacteria, or the recent memory of a global pandemic. A relatively small fraction of microbes cause illness, but those that do can reshape societies, economies, and even politics. Over the last century, vaccines, antibiotics, and sanitation have dramatically cut deaths from many infectious diseases, yet new threats keep emerging as microbes evolve and jump between species.
At the same time, overusing antibiotics in medicine and agriculture has fueled the rise of resistant bacteria that are harder and sometimes nearly impossible to treat. It’s a sobering reminder that our relationship with microbes is a constant negotiation, not a battle we can simply “win.” Public health now leans more on understanding ecosystems of microbes, using targeted treatments, improved hygiene, and global surveillance to prevent outbreaks. It’s about learning to live with the microbial world intelligently, rather than trying to wipe it out.
Harnessing microbes for the future

Once you realize how versatile microbes are, it’s not surprising that scientists and engineers are trying to turn them into tiny workers for solving big problems. Microbes are already used to make insulin, vaccines, enzymes for laundry detergents, and many fermented foods, from yogurt to soy sauce. Today, with advances in genetic engineering and synthetic biology, researchers are designing microbial strains that can produce sustainable fuels, biodegradable plastics, and new medicines. It’s a bit like rewriting the software of life to run different “apps” on a microbial chassis.
There’s also growing interest in using microbes to restore damaged ecosystems. Some projects test microbial mixtures to help degraded soils recover, support coral reef resilience, or improve plant growth with fewer fertilizers. Of course, tinkering with living systems carries real risks, so there’s an ongoing debate about how far and how fast we should push these technologies. Still, it’s hard not to feel a cautious optimism when you realize that the same tiny organisms that shaped our planet’s past might help us repair its future.
Seeing the world through a microbial lens

Once you start noticing microbes, the world stops looking solid and still and starts to feel alive at every scale. The air you breathe, the food you eat, the soil in your garden, the waves in the ocean, and even your own thoughts and moods are all, in some way, touched by invisible life. It can be unsettling to realize how much of our lives depends on something we can’t see, but there’s also something oddly comforting about knowing we’re part of a vast, ongoing conversation between species.
Microbes are not just germs to be feared; they are builders, recyclers, partners, and sometimes dangerous rivals. They turned a hostile early Earth into a living planet and continue to keep that planet running, moment by moment. The more we learn to understand and work with them, instead of pretending we can live without them, the better our chances of building a balanced future. When you look around now, can you imagine how different everything would be if the hidden world of microbes suddenly went silent?



